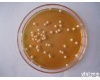
瓶、袋、箱、盒 <em>短小</em><em>芽孢</em>杆菌

wi77348 短小芽孢杆菌芽孢条(芽孢数10的6次方)
- 型号:wi77348
- 供应商:北京若水合科技有限公司
- 供应商报价:面议
- 标签:短小芽孢杆菌芽孢条(芽孢数10的6次方),-1,北京若水合科技有限公司
该芽孢条是将一定数量的芽孢固定于棉滤纸条上,用玻璃纸单独封装。短小芽孢杆菌芽孢 (ATCC27142)用于γ-射线灭菌。 短小芽孢杆菌芽孢条;芽孢种类:短小芽孢杆菌;芽孢数:10的6次方;包装:100片/包 芽孢数:10的7次方,包装:100片/包 货期:要现询。国内不一定有现货 芽孢数:10的8次方 包装:100片/包 货期:要现询。国内不一定有现货 [www.winstrument.cn 注:图片及文字介绍仅供参考,请以实物为准]